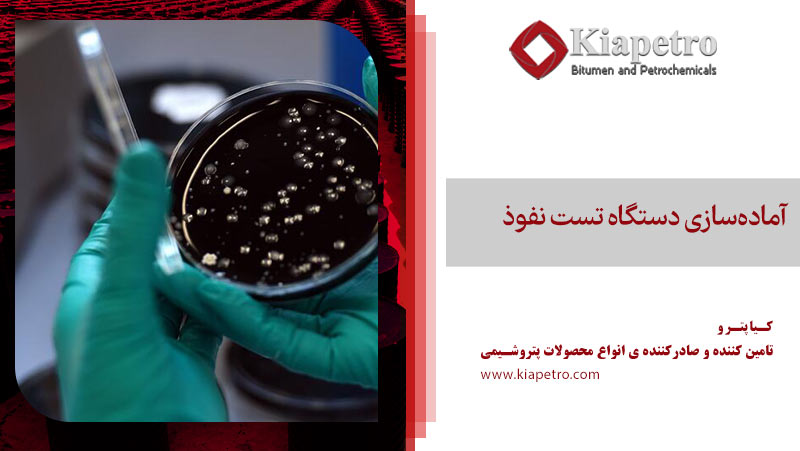
آمادهسازی دستگاه تست نفوذ

تست نفوذ قیر یکی از مهمترین آزمایشها در صنعت راهسازی و ساختوساز است که میتواند تأثیرات زیادی بر کیفیت و دوام پروژهها داشته باشد؛ اما آیا تابهحال به این فکر کردهاید که چرا برخی از جادهها پس از مدت کوتاهی دچار ترک و خرابی میشوند یا چرا برخی از ساختمانها نیاز به تعمیرات مکرر دارند؟
پاسخ این سؤالات ممکن است در کیفیت قیر مورداستفاده نهفته باشد. در این مقاله، به بررسی اهمیت تست نفوذ انواع قیر و تأثیر آن بر پروژههای عمرانی خواهیم پرداخت و نشان خواهیم داد که چگونه این آزمایش میتواند به بهبود کیفیت و کاهش هزینهه
ای نگهداری کمک کند.
تست نفوذ قیر چیست؟
تست نفوذ انواع قیر یکی از آزمایشهای استاندارد برای تعیین قوام و سختی نسبی قیر است. در این آزمایش، یک سوزن استاندارد با وزن 100 گرم به مدت 5 ثانیه در دمای 25 درجه سانتیگراد بهصورت عمودی در نمونه قیر نفوذ میکند. میزان نفوذ سوزن در قیر بر حسب دهم میلیمتر اندازهگیری و گزارش میشود.
این آزمایش برای نامگذاری قیرهای خالص و دمیده استفاده میشود. بهعنوانمثال، قیرهای 50-40 ، 70-60 و 100-85 از جمله قیرهای خالص معمول در راهسازی هستند که عددهای همراه آنها بیانگر محدوده نفوذ قیر است.

مراحل انجام تست نفوذ قیر
تست نفوذ انواع قیر بهعنوان یکی از آزمایشهای استاندارد برای تعیین قوام و سختی نسبی توسط دستگاههای تست نفوذ قیر انجام میشود که اصول و مراحل خاصی را دارد که باید این اصول رعایت شود تا اولاً آزمایش در شرایط مناسبی صورت گیرد دوم این که نتیجه آزمایش مطلوب باشد.

آمادهسازی نمونه قیر
مقدار مناسبی از قیر را تا دمایی بالاتر از نقطه نرمی آن گرم کنید سپس قیر گرم شده را در ظرف مخصوص آزمایش بریزید. این ظرف دارای قطر 5.5 سانتیمتر و ارتفاع 3.5 سانتیمتر است. سطح قیر باید صاف و بدون حباب باشد. برای صافکردن سطح قیر میتوانید از کاردک استفاده کنید.
سردکردن نمونه
ظرف حاوی قیر را در معرض هوای آزمایشگاه قرار دهید تا قیر سرد شود سپس ظرف قیر را به مدت یک الی یک و نیم ساعت در حمام آب با دمای 25 درجه سانتیگراد قرار دهید تا قیر به دمای 25 درجه سانتیگراد برسد.
آمادهسازی دستگاه تست نفوذ
ظرف قیر را از حمام آب خارج کرده و سطح آن را با دستمال نخی خشک کنید. ظرف را زیر دستگاه تست نفوذ قرار دهید بهطوریکه نوک سوزن و نوک تصویر آن در سطح براق قیر بر رویهم منطبق شوند.
انجام تست نفوذ قیر
روشهای انجام آزمایش تست نفوذ قیر متفاوت است؛ اما بهتر است دستگاه را صفر کنید و با زدن کرونومتر، سوزنی که وزن آن با متعلقاتش 100 گرم است را رها کنید. سوزن به مدت 5 ثانیه در قیر نفوذ میکند و مقدار نفوذ سوزن بر حسب دهم میلیمتر اندازهگیری و گزارش میشود.
تکرار آزمایش
این آزمایش برای هر نمونه (هر ظرف) 5 تا 10 بار انجام شده و مقادیر بهدستآمده یادداشت میشود. میانگین اعداد بهدستآمده همان میزان قابلیت نفوذ قیر خواهد بود. این مراحل به شما کمک میکند تا تست نفوذ انواع قیر را بهدرستی انجام دهید و نتایج دقیقی به دست آورید.
مرسومترین خطاها در تست نفوذ قیر
تست نفوذ قیر به طور گستردهای در صنعت انجام میشود تا اطمینان حاصل شود که قیر مورداستفاده دارای ویژگیهای مطلوب برای است. بااینحال، مانند هر آزمایش دیگری، خطاهایی در طول انجام آزمایش رخ دهد. در ادامه به بررسی مرسومترین خطاها در آزمایش اندازهگیری قابلیت نفوذ قیر میپردازیم.

تهیه نمونه و نمونهگیری نامناسب
یکی از شرایط انجام آزمون نفوذ این است که تهیه نمونههای قیر بادقت و به طور یکنواخت انجام شود. اگر نمونهگیری بهدرستی انجام نشود یا بهصورت غیراصولی و غیریکنواخت انجام نشود ممکن است نتایج آزمایش دقیق نباشد و نمایانگر ویژگیهای واقعی قیر نباشد.
نگهداری نامناسب از تجهیزات و سوزنها
تجهیزات آزمایش و سوزنها باید به طور منظم تمیز و نگهداری شوند. هرگونه آلودگی یا خرابی در تجهیزات میتواند نتایج آزمایش را تحتتأثیر قرار دهد و باعث کاهش دقت آن شود و کاهش دقت نیز سبب میشود که نتایج آزمایش غیرواقعی باشد.
خطا در دما و زمان آزمایش
دما و زمان تست نفوذ قیر باید بهدقت کنترل شوند. هرگونه تغییر جزئی در دما یا زمان میتواند نتایج را تحتتأثیر قرار دهد. برای مثال اگر دمای قیر در زمان آزمایش به طور دقیق 25 درجه سانتیگراد نباشد، نتایج آزمایش ممکن است نادرست باشد.
استانداردهای تست نفوذ قیر
استانداردهای مختلفی برای آزمایش نفوذ قیر وجود دارد که هر کدام روشها و جزئیات خاص خود را دارند. هدف از تست نفوذ قیر آگاه شدن از شرایط مطلوب و نامطلوبی است که در قیر استفاده شده وجود دارد. در اینجا به برخی از مهمترین استانداردهای تست نفوذ انواع قیر میپردازیم.

آزمایش نفوذ قیر ASTM D5
نام کامل این تست Standard Test Method for Penetration of Bituminous Materials است که توسط انجمن تست و مواد آمریکا (ASTM) تدوین شده است و روش اندازهگیری میزان نفوذ یک سوزن استاندارد در قیر را در دمای 25 درجه سانتیگراد و تحت بار 100 گرم به مدت 5 ثانیه توضیح میدهد.
این آزمایش دقت بسیاری را دارد بهطوریکه نتیجه این آزمایش بهصورت دهم میلیمتر گزارش میشود که در نوع خود بسیار قابلتوجه است. از این روش تست برای تعیین سختی نسبی قیر استفاده میشود و نتایج آن نیز تا حد زیادی مطلوب است.
آزمایش نفوذ قیر 2AASHTO T49
نام کامل این تست Standard Method of Test for Penetration of Bituminous Materials است که این استاندارد توسط انجمن ایالتی و حملونقل بزرگراههای آمریکا (AASHTO) تدوین شده است و مشابه استاندارد ASTM D5 است.
این استاندارد نیز میزان نفوذ یک سوزن استاندارد در قیر را در دمای 25 درجه سانتیگراد و تحت بار 100 گرم به مدت 5 ثانیه اندازهگیری میکند. نتایج این آزمایش نیز دقت بالایی دارد بهطوریکه نتایج آن بهصورت دهم میلیمتر گزارش میشود.
آزمایش نفوذ قیر EN 1426
نام کامل این تست Bitumen and Bituminous Binders – Determination of Needle Penetration است که این استاندارد توسط کمیته استانداردسازی اروپا (CEN) تدوین شده است و روش اندازهگیری میزان نفوذ یک سوزن استاندارد در قیر را در دمای 25 درجه و تحت بار 100 گرم به مدت 5 ثانیه توضیح میدهد.
نتیجه این آزمایش نیز دقت بالایی دارد و بهصورت دهم میلیمتر گزارش میشود. این استاندارد بیشتر در اروپا و آسیا به کار میرود و مشابه استانداردهای ASTM D5 و AASHTO T49 است؛ بنابراین برای شرایط آبوهوایی کشورمان مناسب است.
آزمایش نفوذ قیر IP 49
نام کامل این تست Determination of Penetration of Bituminous Materials است که این استاندارد توسط مؤسسه نفت (IP) تدوین شده است و روش اندازهگیری میزان نفوذ یک سوزن استاندارد در قیر را در دمای 25 درجه سانتیگراد و تحت بار 100 گرم به مدت 5 ثانیه توضیح میدهد.

آزمایش نفوذ قیر JIS K 2207
نام کامل این تست Testing Methods for Penetration of Bituminous Materials است که این استاندارد توسط سازمان استانداردهای صنعتی ژاپن (JIS) تدوین شده است و روش اندازهگیری میزان نفوذ یک سوزن استاندارد در قیر را در دمای 25 درجه سانتیگراد و تحت بار 100 گرم به مدت 5 ثانیه توضیح میدهد.
جدول اطلاعات آزمایش قیر
آزمایشهای بسیاری در سطح جهان برای تست نفوذ قیر انجام میشود که هر کدام تعریفهای مخصوص به خود را دارد و این مسئله برای جدول اطلاعات آزمایش قیر نفوذی نیز صادق است؛ اما بهطورکلی یک جدول استاندارد حاوی اطلاعات زیر است.
| نام آزمایش | هدف آزمایش | روش آزمایش | واحد اندازهگیری |
| تست نفوذ | تعیین سختی قیر | اندازهگیری میزان نفوذ یک سوزن استاندارد در قیر در دمای ۲۵ درجه سانتیگراد | دهم میلیمتر |
| تست ویسکوزیته | تعیین مقاومت قیر | اندازهگیری مقاومت قیر در برابر جریان در دماهای مختلف | پاسکال بر ثانیه |
| نقطه نرمی قیر | تعیین روانی قیر | دمایی که در آن قیر از حالت جامد به مایع تبدیل میشود | درجه سانتیگراد |
| نقطه اشتعال قیر | نقطه اشتعال قیر | حداکثر دمایی که قیر میتواند گرم شود بدون ایجاد شعله روان شود | درجه سانتیگراد |
| اکتیویته قیر | نقطه کشش قیر | اندازهگیری میزان کششپذیری قیر قبل از شکستن | سانتیمتر |
| وزن مخصوص قیر | تعیین وزن حجمی | نسبت وزن حجم معینی از قیر به وزن آب همحجم آن در دمای مشخص | گرم بر سانتیمتر مکعب |
| حلالیت قیر | میزان حلالیت قبر | اندازهگیری میزان حلالیت قیر در حلالهای مشخص | درصد |
| نقطه شکست قیر | تعیین نقطه شکست | دمایی که در آن قیر شروع به شکست میکند | درجه سانتیگراد |
| چسبندگی قیر | میزان چسبندگی | اندازهگیری میزان چسبندگی قیر به مصالح سنگی | درصد |
کیاپترو پیشگام در صنعت قیر
شرکت کیاپترو یکی از پیشروان تولید و تأمین فرآوردههای قیری و پتروشیمی در ایران است. این شرکت با تأکید بر کیفیت محصولات و رضایت مشتری، توانسته است جایگاه ویژهای در بازارهای داخلی و بینالمللی کسب کند.
کیاپترو با بهرهگیری از تیمی متخصص و ماشینآلات بهروز، محصولات متنوعی از جمله انواع قیر نفوذی، قیرهای امولسیونی، قیرهای پلیمری و…. را تولید و عرضه میکند. این شرکت با ایجاد شبکهای منسجم بین تأمینکنندگان و مصرفکنندگان، علاوه بر تأمین محصولات با کیفیت، قیمتهای رقابتی نیز ارائه میدهد.
سخن پایانی
تست نفوذ قیر با تمام سادگی ظاهریاش، یکی از کلیدیترین آزمایشها در صنعت راهسازی و ساختوساز است. این آزمایش نه تنها کیفیت و عملکرد قیر را مشخص میکند، بلکه به مهندسان و متخصصان کمک میکند تا بهترین مواد را برای پروژههای خود انتخاب کنند.
سؤالات متداول
- تست نفوذ قیر چیست؟
تستی برای اندازهگیری میزان نفوذ یک سوزن استاندارد در قیر در دمای ۲۵ درجه سانتیگراد
- واحد اندازهگیری نفوذ قیر چیست؟
دهم میلیمتر
- چه استانداردهایی برای تست نفوذ قیر وجود دارد؟
ASTM D5 و IP 49/58.












بدون دیدگاه